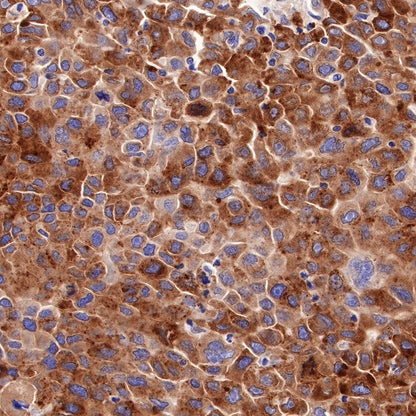

Product Details
Product Details
Product Specification
| Host | Rabbit |
| Antigen | Asialoglycoprotein Receptor 1 |
| Synonyms | ASGP-R 1, ASGPR 1, C-type lectin domain family 4 member H1, Hepatic lectin H1, HL-1, ASGR1, CLEC4H1 |
| Immunogen | Recombinant Protein |
| Location | Secreted, Membrane |
| Accession | P07306 |
| Clone Number | SDT-292-48 |
| Antibody Type | Recombinant mAb |
| Application | WB, IHC-P, ICC, ICFCM |
| Reactivity | Hu, Ms, Rt |
| Purification | Protein A |
| Concentration | 0.5 mg/ml |
| Physical Appearance | Liquid |
| Storage Buffer | PBS, 40% Glycerol, 0.05% BSA, 0.03% Proclin 300 |
| Stability & Storage | 12 months from date of receipt / reconstitution, -20 °C as supplied |
Dilution
| application | dilution | species |
| WB | 1:1000-1:5000 | null |
| IHC-P | 1:2000 | null |
| ICFCM | 1:5000 | null |
| ICC | 1:500 | null |
Background
Asialoglycoprotein receptors (ASGP-R; exist as subtypes 1 and 2) are located on the surface of hepatic cell membranes and are involved in the binding and endocytosis of glycoproteins that have exposed carbohydrate or N-acetylgalactosamine residues. In addition, the decreased level of ASGP-R on the hepatic cells has been shown to correlate clinically with the degree of liver function retained due to the development of cirrhosis, cancer, or viral hepatitis [PMID: 20641215].
Picture
Picture
Western Blot



FC

Flow cytometric analysis of 4% PFA fixed 90% methanol permeabilized HeLa (Human cervix adenocarcinoma epithelial cell, left) / HepG2 (Human hepatocellular carcinoma epithelial cell, Right) cells labelling Asialoglycoprotein Receptor 1 antibody at 1/5000 dilution (0.01 μg) / (Red) compared with a Rabbit monoclonal IgG (Black) isotype control and an unlabelled control (cells without incubation with primary antibody and secondary antibody) (Blue). Goat Anti - Rabbit IgG Alexa Fluor® 488 was used as the secondary antibody.Negative control: HeLa
Immunohistochemistry






Immunocytochemistry

ICC shows positive staining in HepG2 cells. Anti-ASGR1 antibody was used at 1/500 dilution (Green) and incubated overnight at 4°C. Goat polyclonal Antibody to Rabbit IgG - H&L (Alexa Fluor® 488) was used as secondary antibody at 1/1000 dilution. The cells were fixed with 100% ice-cold methanol and permeabilized with 0.1% PBS-Triton X-100. Nuclei were counterstained with DAPI (Blue).Counterstain with tubulin (Red).

Negative control:ICC shows negative staining in HeLa cells. Anti-ASGR1 antibody was used at 1/500 dilution and incubated overnight at 4°C. Goat polyclonal Antibody to Rabbit IgG - H&L (Alexa Fluor® 488) was used as secondary antibody at 1/1000 dilution. The cells were fixed with 100% ice-cold methanol and permeabilized with 0.1% PBS-Triton X-100. Nuclei were counterstained with DAPI (Blue).Counterstain with tubulin (Red).